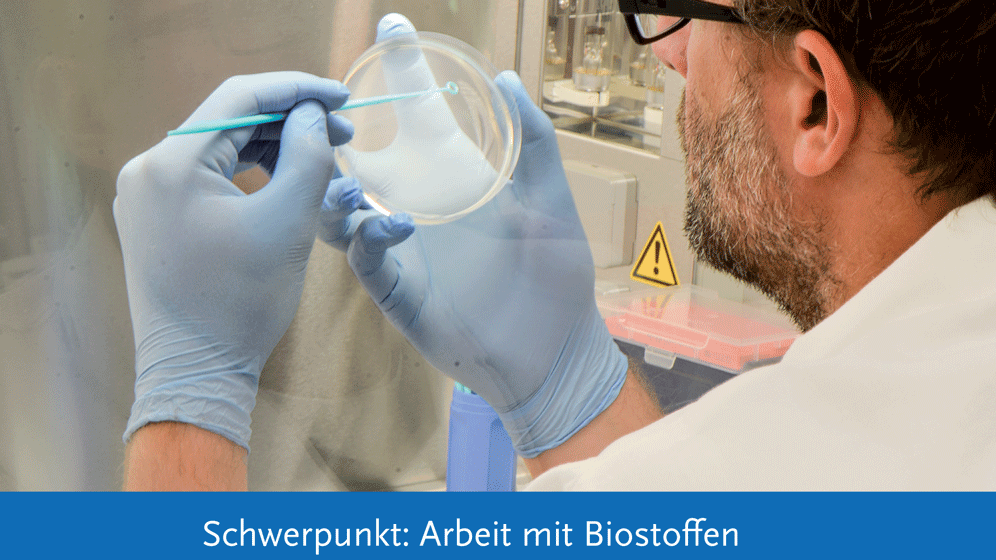
Biostoffe

Wirkstoffe in Antibiotika oder gegen Krebs sind Naturstoffe, welche Bakterien oder Pilze aufbauen. Eine Herstellung dieser Naturstoffe im Labor ist, wenn überhaupt, nur sehr schwer möglich. Ausgangsbasis für eine große Zahl solcher Verbindungen sind Polyketide, Kohlenstoffketten, bei denen jedes zweite Atom eine Doppelbindung zu einem Sauerstoffatom besitzt.
Schrittweiser Aufbau der Naturstoffe
Sie entstehen in der Zelle eines Mikroorganismus durch Polyketidsynthasen (PKS). Der schrittweise Aufbau der gewünschten Moleküle erfolgt bei Typ II PKS-Systemen in der ersten Stufe durch die Zusammenarbeit von vier Proteinen. In einer zweiten Stufe werden sie dann durch weitere Enzyme zum gewünschten Naturstoff modifiziert. Solche bakteriell hergestellten Naturstoffe sind beispielsweise die klinisch genutzten Tetracyclin-Antibiotika oder das Krebsmedikament Doxorubicin.
Zu den Schritten der zweiten Stufe liegen viele Untersuchungen vor. Doch zu den grundsätzlichen Arbeitsweisen der ersten Stufe dieser molekularen Wirkstoff-Fabriken fehlen Studien. In dieser Stufe ist das sehr reaktive Polyketid-Zwischenprodukt am Enzymkomplex gebunden und geschützt, sodass eine spontane Reaktion nicht möglich ist.
Röntgenstrukturanalyse liefert Ergebnisse
Mit diesem Projekt beschäftigte sich nun eine Kooperation zwischen den Arbeitsgruppen von Michael Groll, Professor für Biochemie an der TU München, und Helge Bode, Professor für Molekulare Biotechnologie der Goethe-Universität Frankfurt. Durch eine Röntgenstrukturanalyse konnten sie erstmals Komplexe der verschiedenen Partner-Proteine der Typ II Polyketidsynthase analysieren. Das habe zum Verständnis des ganzen katalytischen Zyklus beigetragen.
Durch diese Analysen ist künftig ein gezielter Eingriff in die zentralen biochemischen Prozesse möglich, um die Grundstrukturen zu verändern. Eine Beschränkung auf die dekodierenden Enzyme falle somit weg. Bis verbesserte Antibiotika und andere Medikamente entstehen, ist es zwar ein weiter Weg, aber beide Gruppen sind optimistisch, dass nun auch die noch fehlenden Teile der molekularen Fabrik in Struktur und Mechanismus aufgeklärt werden können.
Literatur:
Alois Bräuer, Qiuqin Zhou, Gina L.C. Grammbitter, Maximilian Schmalhofer, Michael Rühl, Ville R.I. Kaila, Helge B. Bode und Michael Groll: Structural snapshots of the minimal PKS system responsible for octaketide biosynthesis. Nature Chemistry 06.07.2020 – DOI: 10.1038/s41557-020-0491-7.
Quelle: TUM
Artikel teilen